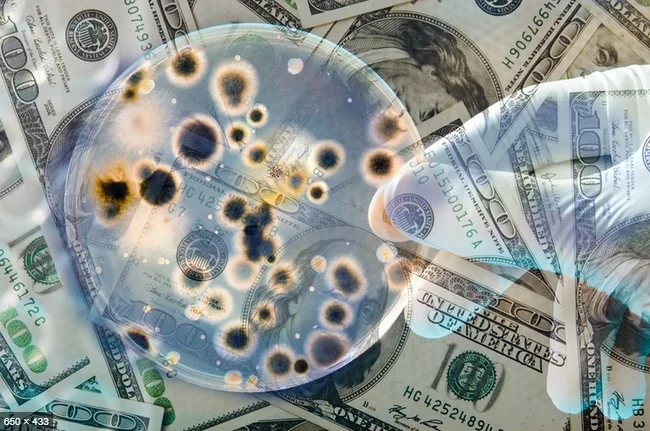

Мы продолжаем работать!
30 марта 2020
Несмотря на столь суровые изменения в мире и в стране наша компания продолжает свою деятельность! Мы реализуем насосное, отопительное оборудование и оборудование для водоподготовки. А также комплектующие, запчасти и аксессуары для этих групп товаров. Если Вы опасаетесь приезжать за покупкой, мы сможем организовать доставку к Вам.
Желаем Вам и вашим близким оставаться здоровыми и не поддаваться панике.
Коллектив компании ООО "Кельвинстрой".